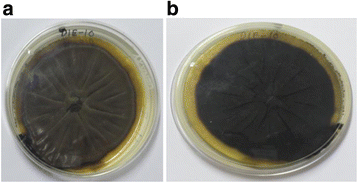
【文献解析】Cladosporol A通过ROS介导的自噬流触发乳腺癌细胞凋亡敏感性

文献检索
期刊检索
品牌检索
基金检索
学者检索
生知快讯
最新资讯
更多
【文献解析】从低处理量人血浆中选择性分离细胞外囊泡作为液体活检的转化策略
1. 领域背景与文献引入文献英文标题:Selective isolation of extracellular vesicles from minimally processed human plasma as a translational strategy for liquid biopsies;发表期刊:Biomarker Research;影响因子:未公开;研究领域:肿瘤液体活检、细胞外囊泡分离与生物标志物研究。细胞外囊泡(EVs)作为介导细胞

【文献解析】达尔西利(一种周期蛋白依赖性激酶4/6抑制剂)在中国晚期乳腺癌患者中的I期研究
1. 领域背景与文献引入文献英文标题:A phase 1 study of dalpiciclib, a cyclin-dependent kinase 4/6 inhibitor in Chinese patients with advanced breast cancer;发表期刊:Biomark Res;影响因子:未公开;研究领域:肿瘤学-晚期乳腺癌靶向治疗细胞周期失调是恶性肿瘤的核心特征之一,周期蛋白D(CCND)-周期蛋白依赖
【文献解析】Cladosporol A通过ROS介导的自噬流触发乳腺癌细胞凋亡敏感性
1. 领域背景与文献引入文献英文标题:Cladosporol A triggers apoptosis sensitivity by ROS-mediated autophagic flux in human breast cancer cells;发表期刊:BMC Cell Biology;影响因子:未公开;研究领域:肿瘤学(乳腺癌天然产物靶向治疗)领域共识:天然产物及其衍生物是抗癌药物的重要来源,过去50年约47%的抗癌药
